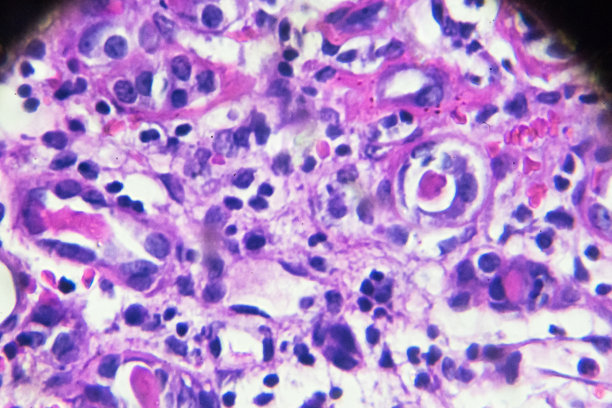

肾小球

请先登录后再下载
58明星,肾小球,肾元,输尿管,肾炎综合征,泌尿系统,血管球性肾炎,尿液,肾病,生理学,肾盂肾炎,神经系统,急诊医学,身体检查,炎症,生病,人体内脏器官,显微镜载玻片,人体结构,细胞,疼痛,药,分析,横截面,凌乱,失败,放大效果,有序,红色,炮弹果属,肾病综合症,多囊性卵巢综合症,人类肾脏,健康保健,健康生活方式,摄影,人,水平画幅,部分,关爱,图像